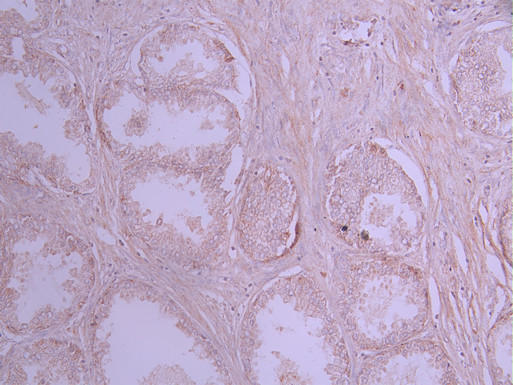

-
中文名稱:HK1 Recombinant Monoclonal Antibody
-
貨號:CSB-RA825804A0HU
-
規格:¥1320
-
圖片:
-
Western Blot
Positive WB detected in: U-87MG whole cell lysate(30μg), HT-29 whole cell lysate(30μg), MCF-7 whole cell lysate(30μg), HEK293 whole cell lysate(30μg), NIH/3T3 whole cell lysate(30μg), Mouse brain tissue lysate(30μg), Rat brain tissue lysate(30μg)
All lanes: Hexokinase 1 antibody at 1:1000
Secondary
Goat polyclonal to rabbit IgG at 1/40000 dilution
Predicted band size: 102 kDa
Observed band size: 120-130 kDa
Exposure time:2min -
IHC image of CSB-RA825804A0HU diluted at 1:100 and staining in paraffin-embedded human prostate cancer performed on a Leica BondTM system. After dewaxing and hydration, antigen retrieval was mediated by high pressure in a citrate buffer (pH 6.0). Section was blocked with 10% normal goat serum 30min at RT. Then primary antibody (1% BSA) was incubated at 4°C overnight. The primary is detected by a Goat anti-rabbit polymer IgG labeled by HRP and visualized using 0.05% DAB.
-
Overlay Peak curve showing MCF-7 cells stained with CSB-RA825804A0HU (red line) at 1:100. The cells were fixed in 4% formaldehyde and permeated by 0.2% TritonX-100 for 10min. Then 10% normal goat serum to block non-specific protein-protein interactions followed by the antibody (1ug/1*106cells) for 45min at 4℃. The secondary antibody used was FITC-conjugated goat anti-rabbit IgG (H+L) at 1/200 dilution for 35min at 4℃.Control antibody (green line) was Rabbit IgG (1ug/1*106cells) used under the same conditions. Acquisition of >10,000 events was performed.
-
-
其他:
產品詳情
-
Uniprot No.:
-
基因名:
-
別名:Hexokinase-1 (EC 2.7.1.1) (Brain form hexokinase) (Hexokinase type I) (HK I), HK1
-
反應種屬:Human, Mouse, Rat
-
免疫原:A synthesized peptide from human HK1 protein
-
免疫原種屬:Homo sapiens (Human)
-
標記方式:Non-conjugated
-
克隆類型:Monoclonal
-
抗體亞型:Rabbit IgG
-
純化方式:Affinity-chromatography
-
克隆號:14E8
-
濃度:It differs from different batches. Please contact us to confirm it.
-
保存緩沖液:Preservative: 0.03% Proclin 300
Constituents: 50% Glycerol, 0.01M PBS, PH 7.4 -
產品提供形式:Liquid
-
應用范圍:ELISA, WB, IHC, FC
-
推薦稀釋比:
Application Recommended Dilution WB 1:500-1:2000 IHC 1:50-1:200 FC 1:50-1:200 -
Protocols:
-
儲存條件:Upon receipt, store at -20°C or -80°C. Avoid repeated freeze.
-
貨期:Basically, we can dispatch the products out in 1-3 working days after receiving your orders. Delivery time maybe differs from different purchasing way or location, please kindly consult your local distributors for specific delivery time.
-
用途:For Research Use Only. Not for use in diagnostic or therapeutic procedures.
引用文獻
- The nuclear receptor NR6A1 plays an oncogenic role through reprogramming glycolysis in tumors X Liu, Y Li, X Rao, S Xie, Z Rong, L Yang, Z Mao,Biological Research,2025
相關產品
靶點詳情
-
功能:Catalyzes the phosphorylation of various hexoses, such as D-glucose, D-glucosamine, D-fructose, D-mannose and 2-deoxy-D-glucose, to hexose 6-phosphate (D-glucose 6-phosphate, D-glucosamine 6-phosphate, D-fructose 6-phosphate, D-mannose 6-phosphate and 2-deoxy-D-glucose 6-phosphate, respectively). Does not phosphorylate N-acetyl-D-glucosamine. Mediates the initial step of glycolysis by catalyzing phosphorylation of D-glucose to D-glucose 6-phosphate. Involved in innate immunity and inflammation by acting as a pattern recognition receptor for bacterial peptidoglycan. When released in the cytosol, N-acetyl-D-glucosamine component of bacterial peptidoglycan inhibits the hexokinase activity of HK1 and causes its dissociation from mitochondrial outer membrane, thereby activating the NLRP3 inflammasome.
-
基因功能參考文獻:
- Mutation in c-Src phosphorylation site of either HK1 or HK2 remarkably abrogates the stimulating effects of c-Src on glycolysis, cell proliferation, migration, invasion, tumorigenesis and metastasis PMID: 28054552
- HK1 competes with SOD1 G93A mutant from familial amyotrophic lateral sclerosis cases for binding VDAC1. PMID: 27721436
- HK1 protein levels was decreased after luteolin treatment and partly restored when co-treated with luteolin and miR-34a inhibitor. PMID: 29054762
- The pathogenic nature of the identified missense mutations was confirmed by biochemical and 3-dimensional structural analysis. The effects of the novel splice site mutation c.873-2A>G were studied at the level of pre-mRNA processing, and confirmed at the protein level. Four of the 6 mutations studied were new. PMID: 27282571
- STAT3 expression is upregulated in both HBV- and HCV-related hepatocellular carcinoma (HCC), while hexokinase II (HK-II) is predominantly upregulated and correlated to STAT3 in HBV-related HCC PMID: 26889748
- Russe type hereditary motor and sensory neuropathy belongs to the most frequent types of hereditary neuropathy in the Czech Republic, which affects Roma and is caused by a HK1 mutation. PMID: 26822750
- Data suggest that overexpression of hexokinase 1 (HK1) may act as a significant biomarker of poor prognosis for patients with colorectal cancer (CRC). PMID: 26476538
- 4-hydroxytamoxifen resistance in breast cancer cells is suppressed by curcumin, which targets the SLUG/Hexokinase 2 pathway PMID: 27012210
- Our results suggest that overexpression of PKM2 and HK1, especially the latter, significantly associates with lymphatic metastasis, advanced clinical staging and unfavorable prognosis in gastric cancer. PMID: 26464675
- The transport of glucose across the cell membrane by glucose transporters (GLUTs) and intracellular phosphorylation by hexokinases (HKs) are the initial steps of the glycolytic pathway. PMID: 25766729
- HK1 and HK2 expression alterations were detected, that could be explained by common deregulation mechanisms of these genes in colorectal tumors. The HK3 expression level was significantly increased in 60% of samples. PMID: 26855992
- Data indicate a missense mutation in hexokinase 1 (HK1) c.2539G > A, p.Glu847Lys, tracking with disease in all affected family members. PMID: 26427411
- HK1 expression is highly enriched in neurons compared to astrocytes in the cerebral cortex. PMID: 25904018
- HK-1 plays a non-metabolic role in HIV-1 infected macrophages by binding to mitochondria thereby maintaining mitochondrial integrity. PMID: 25602755
- The present study was designed to evaluate the involvement of hexokinase and CPT-1 in the cell growth and proliferation of human prostate cancer cell lines, PC3, and LNCaP-FGC-10. PMID: 25501281
- HK1 is expressed in retina, with two abundant isoforms expressed at similar levels. The Glu847Lys mutation is located at a highly conserved position in the protein, outside the catalytic domains. PMID: 25190649
- Here, we identified HK1 as a novel causative gene for adRP. This is the first report that associates the glucose metabolic pathway with human retinal degenerative disease, suggesting a potential new disease mechanism. PMID: 25316723
- Hexokinase 1 (HK1) is a mitochondrial protein that controls the tramsmembrane potential and blocks apoptotic signals at the mitochondria. PMID: 24018046
- An increased ratio of HK1 protein in the extrasynaptic membrane/mitochondrial fraction of prefronal cortex was found in subjects with schizophrenia, suggesting that HK1 protein is abnormally partitioned in this illness PMID: 24560881
- A genetic association of myelomeningocele in Chile found polymorphisms for HK1. PMID: 23427181
- We detected mutation in the NDRG1 gene in two families and mutation in the HK1 gene in the other two families. These mutations cause Charcot-Marie-Tooth Disease, Type 4D and Charcot-Marie-Tooth disease, type 4g, respectively. PMID: 23996628
- Dominant, diazoxide-responsive HI in this family maps to a novel locus on Chr10q21-22. Disease-associated variants were found in non-coding regions of HK1 PMID: 23859901
- Data indicate that the most frequent form is SH3TC2 gene (CMT4C; 57.14%), followed by HK1 gene causative of CMT4G (CMT4G/HMSN-Russe 25%) and NDRG1 p.R148X in CMT type 4D (CMT4D/HMSN-Lom; 17.86%). PMID: 22978647
- The screening for novel Parkin substrate(s) identified mitochondrial hexokinase I (HKI) as a candidate. PMID: 23068103
- A key K8/K18 regulation of glucose metabolism in normal and cancerous hepatic cells through differential modulations of mitochondrial hexokinase status and insulin-mediated signaling. PMID: 23164509
- This study proposed that HK1 mitochondrial detachment could be linked to these disorders through impaired energy metabolism, increased vulnerability to oxidative stress, and impaired brain growth and development. PMID: 22018957
- An association is noted between the rs7072268 T-allele in HK1 and an increased blood glucose in non-diabetic individuals and a nominal association with type 2 diabetes prior to Bonferroni correction. PMID: 21781351
- Abeta-induced cellular redistribution and inactivation of neuronal HKI play important roles in oxidative stress and neurodegeneration in Alzheimer's disease PMID: 21179577
- FimA strengthens the VDAC1-hexokinase(I and II) interaction and prevents dissociation of hexokinase from VDAC1 triggered by apoptotic stimuli. PMID: 20347420
- The comprehensive sequencing analysis and fine mapping approximately 26 kb of fully characterised sequence spanning the upstream exons of Hexokinase 1 (HK1), is reported. PMID: 19536174
- REVIEW: Gene expression and biological significance of HK1 and HKR isoforms of hexokinase in erythroid cells. PMID: 12432216
- Glucose 6-phosphate binds to human brain hexokinase in mitochondria PMID: 16166083
- The role of the HK1 interdomain alpha-helix at the interdomain signal transduction was studied. PMID: 17080299
- Neither human hexokinase-1 nor human inorganic pyrophosphatase expression segregated concordantly with human cytoplasmic glutamic-oxaloacetic transaminase expression. PMID: 17494625
- single nucleotide polymorphisms on gene involved with glucose metabolism and obesity may be associated with increased susceptibility to spina bifida PMID: 18212354
- interference with the binding of Hexokinase-I to mitochondria by VDAC1-derived peptides may offer a novel strategy by which to potentiate the efficacy of conventional chemotherapeutic agents PMID: 18308720
- results point to HK-I and HK-II as promoting tumor cell survival through binding to VDAC1, thereby inhibiting cytochrome c release and apoptotic cell death. PMID: 19049977
- Glycated hemoglobin levels are associated with genetic variation of HK1. PMID: 19096518
- The expression pattern of HK1 is reported in newly diagnosed esophageal adenocarcinoma by means of immunohistochemistry. PMID: 19554504
- reduced erythroid transcription of HK1 together with aberrant splicing of both hexokinase-1 and red cell specific-hexokinase results in hexokinase deficiency and mild chronic hemolysis. PMID: 19608687
- HK1 may influence A1C levels through its anemic effect or its effect on glucose metabolism in erythrocytes, which may have implications for type 2 diabetes diagnosis and care. PMID: 19651813
- Using shotgun mass spectrometry, we found this protein differentially expressed in the dorsolateral prefrontal cortex from patients with schizophrenia. PMID: 19165527
- This protein has been found differentially expressed in the temporal lobe from patients with schizophrenia. PMID: 19034380
顯示更多
收起更多
-
相關疾病:Hexokinase deficiency (HK deficiency); Neuropathy, hereditary motor and sensory, Russe type (HMSNR); Retinitis pigmentosa 79 (RP79)
-
亞細胞定位:Mitochondrion outer membrane; Peripheral membrane protein. Cytoplasm, cytosol.
-
蛋白家族:Hexokinase family
-
組織特異性:Isoform 2: Erythrocyte specific (Ref.6). Isoform 3: Testis-specific. Isoform 4: Testis-specific.
-
數據庫鏈接: